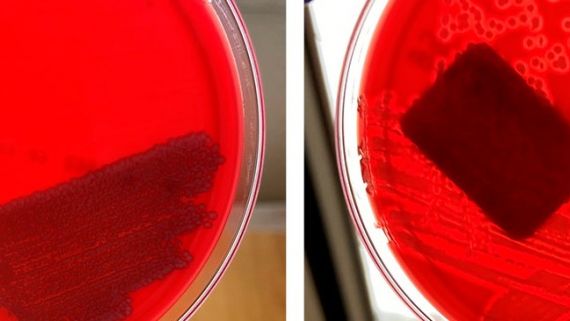
E. coli n&atilde;o hemol&iacute;tica (esquerda) e&nbsp;E. coli hemol&iacute;tica (direita)

Diagnóstico laboratorial: Glaesserella (Haemophilus) parasuis (Doença de Glässer )
Que métodos de diagnóstico laboratorial posso usar para diagnosticar a doença de Glässer? Qual devo escolher de acordo com a situação? Como posso interpretar os resultados?